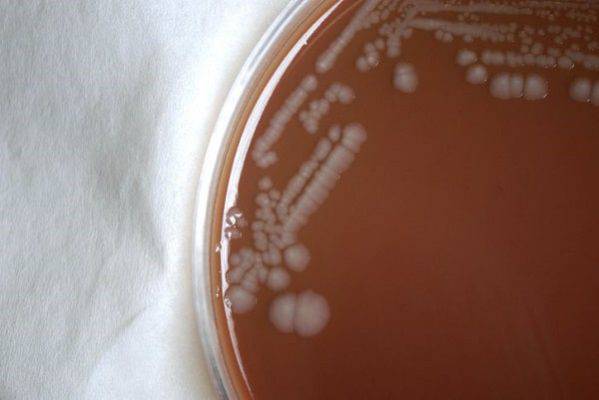

Allarme per sifilide e malattie veneree: boom di infezioni a Bologna, preoccupazione per la mancata prevenzione e i rapporti omosessuali.
La commissione Sanità del Comune di Bologna lancia l’allarme: negli ultimi quindici anni, nel capoluogo emiliano, c’è stata una crescita esponenziale dei casi di malattie veneree. Ogni anno si contano fra 100 e 300 nuovi casi, la sifilide ha avuto un incremento del 400%: questi alcuni dei dati diffusi oggi.
Vuoi restare aggiornato sulla cronaca italiana? Clicca qui
I dati sulle malattie veneree a Bologna e la prevenzione
“Per la maggior parte si tratta di uomini con una maggiore incidenza tra gli omosessuali”, spiega Antonietta D’Antuono, responsabile del centro malattie sessualmente trasmissibili del dipartimento di dermatologia del Policlinico Sant’Orsola, parlando degli oltre cento casi di sifilide che si contano ogni anno, poi ci sono 300 quelli di clamidia, per lo più donne, e 170 casi di gonorrea. In tutto, si parla di 3500 persone che si rivolgono al centro come primo accesso ogni anno.
Secondo la dottoressa, la prevenzione “dovrebbe uscire dalle scuole e dagli ospedali” e raggiungere fasce di popolazioni diverse, anche perché “c’è scarsa informazione su queste malattie e poca paura delle infezioni. Non se ne sente parlare”. E a proposito di prevenzione, gli utenti del centro ne fanno ben poca: “il 50% dichiara di non usare alcun tipo di contraccettivi e solo l’8% dice di utilizzare sempre il preservativo”.
Leggi tutte le nostre notizie di viaggi, cronaca, attualità e curiosità anche su Google News






